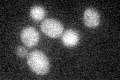
YJL089W
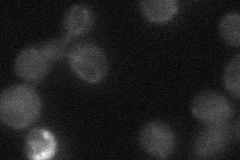
YJL089W

View description
C6 zinc cluster transcriptional activator that binds to the carbon source-responsive element (CSRE) of gluconeogenic genes; involved in the positive regulation of gluconeogenesis; regulated by Snf1p protein kinase; localized to the nucleus
Localization:
Intensity:
Fold change:
Significance:
-
C’ GFP library in SD
below threshold17.53 -
N' NOP1pr-GFP in SD

nucleus60.0303 -
N' TEF2pr-mCherry in SD

nucleus21.9652 -
N' NATIVEpr-GFP in SD
below threshold16.8314 -
N' TEF2pr-VC and Cyto-VN in SD

#N/A0 -
C’ GFP library in SD+DTT

cytosol15.640.89No -
C’ GFP library in SD+H2O2

cytosol17.581No -
C’ GFP library in Starvation Media

cytosol14.640.83No -
C’ GFP library on the background of Pup2-DaMP

below threshold -
C’ GFP library on the background of CCT mutant

below threshold18.02771.02798No
